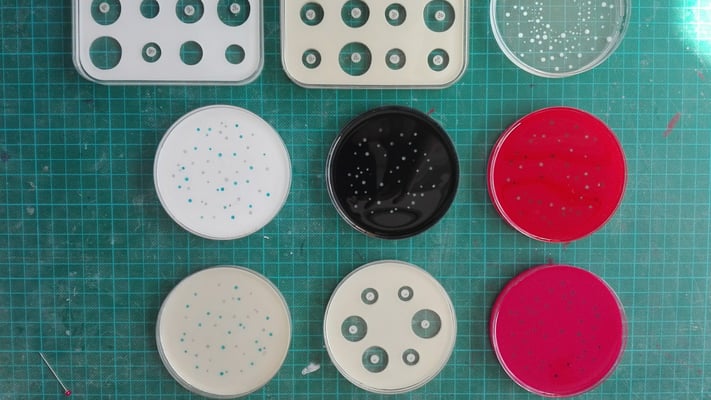

Sculpture - show-room (cosmétiques)
création d'un objet sur-mesure lumineux et interactif
brin de cheveu (échelle macro) avec coupe transversale
Pour la scénographie d'un show-room d'une grande marque de cosmétique (colorants capillaires) ,
Le Garage Fourgon a dirigé la création et la fabrication d'une sculpture interactive et lumineuse représentant un brin de cheveux grossi au microscope.
En surface ; un dégradé d'écailles acajou et ambré, et, en haut : une coupe transversale montrant les fibrilles qui composent l'intérieur du cheveu.
Cet objet complexe est le fruit d'un travail de longue haleine et d'une collaboration de plusieurs savoir-faire :
Commanditaire: Ergoconcept -Evalomel
Maître d'ouvrage: Le Garage Fourgon
modélisation et l'impression 3D: Holospasm studio
Led et programme éclairage: Studio Muybridge
Socle: David Posth-Kholer
2021
Boîtes de Petri factices pour laboratoire industriel (microscopes)
Boîtes de Petri factices en résine
expériences reproduites d'après un cahier des charges précis pour 7 types de cas différents
utilisées comme démonstration pour tester les appareils d'observation (microscopes) fabriqués par le client .
Série de 350 pièces.